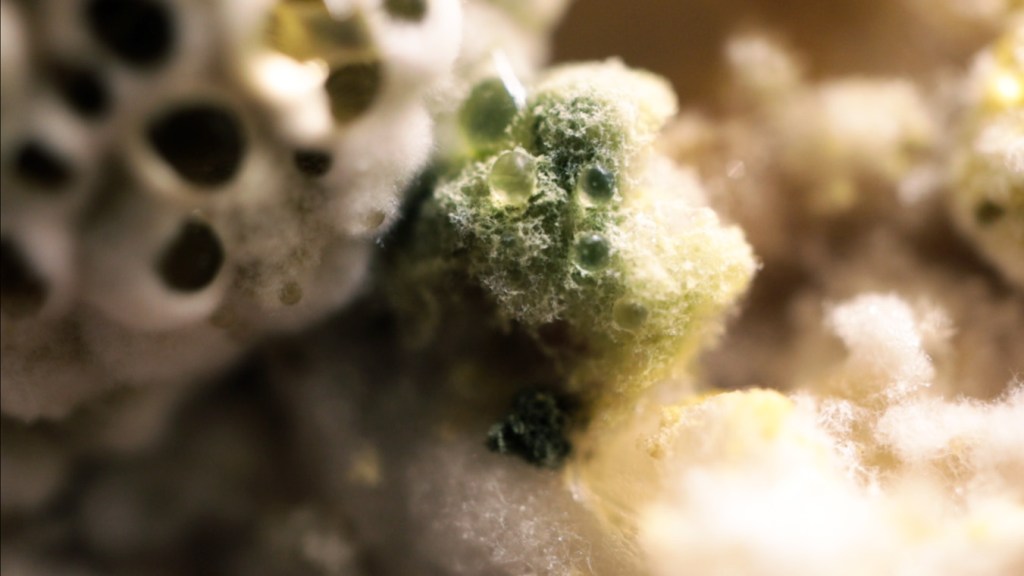

‘The Hairless Communiqué’ is a unique, independently-created film jointly written and produced by Tatyana Waldron and M. S. Waldron, directed and edited by Tatyana. Both are visual and sound artists, and so elements of both these creative forms are heavily imbued into the film. The relation of the self to nature, the nature of identity and perception, and the connection between all of these things is explored in a surreal – sometimes grotesque, sometimes absurd – journey to the core of being.
Principal photography is well underway on this project, with a majority of the footage having been shot. Funding is now being sought to complete the rest of the footage.
We hope you will join us on this journey!
As we add new footage to the film, we’ll be posting more fresh (but not too revealing!) stills here and maybe some glimpses behind the scenes as well…